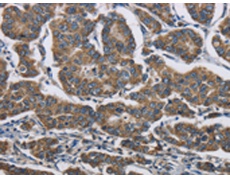
一抗

中文名稱: 兔抗AGER多克隆抗體
|
Background: |
The advanced glycosylation end product (AGE) receptor encoded by this gene is a member of the immunoglobulin superfamily of cell surface receptors. It is a multiligand receptor, and besides AGE, interacts with other molecules implicated in homeostasis, development, and inflammation, and certain diseases, such as diabetes and Alzheimer's disease. Many alternatively spliced transcript variants encoding different isoforms, as well as non-protein-coding variants, have been described for this gene. |
|
Applications: |
ELISA, WB, IHC |
|
Name of antibody: |
AGER |
|
Immunogen: |
Fusion protein of human AGER |
|
Full name: |
Advanced glycosylation end product-specific receptor |
|
Synonyms: |
RAGE |
|
SwissProt: |
Q15109 |
|
ELISA Recommended dilution: |
2000-5000 |
|
IHC positive control: |
Human breast cancer and Human gastric cancer |
|
IHC Recommend dilution: |
100-300 |
|
WB Predicted band size: |
43 kDa |
|
WB Positive control: |
231 cells |
|
WB Recommended dilution: |
500-2000 |


 購物車
購物車 幫助
幫助
 021-54845833/15800441009
021-54845833/15800441009